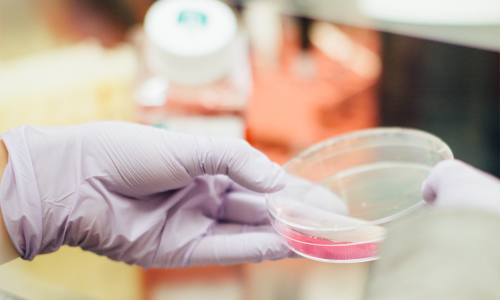

healthy and trust company
믿음가는 의료기
언제나 믿음가는 제품으로 여러분과
가족의 건강 모두를 생각합니다
서울특별시 강남구 강남동 776-9 사업자등록번호 : 123-45-6789 대표 : 김신성
TEL : 1500-1234 FAX : 1500-1235 E-MAIL : webad@happycgi.com Hosting by SITEWA
Copyright(c) 2026 의료기 All Rights Reserved











 로그인
로그인 회원가입
회원가입